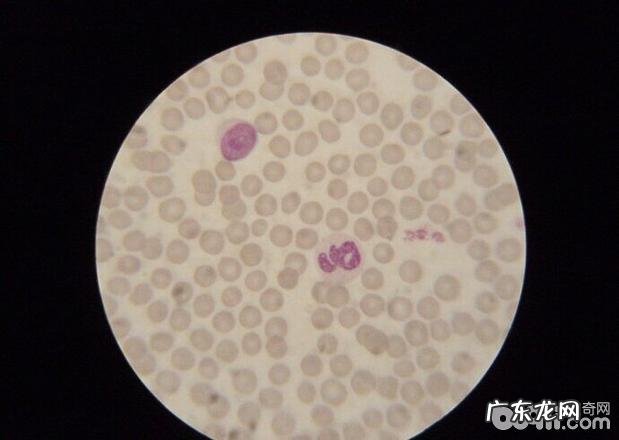
犬附红体病的确诊与医治

③保持治疗法,静注液體和多种多样碳水化合物;
④因人体长期性缺铁性贫血脾脏肿大,等候心电监护修复开展肝脏切除手术治疗 。
历经一个半半月的医治,该犬于10月中下旬痊愈住院 。各类临床症状基础恢复过来 。
2、病案二
2.1 病发状况
博美犬(详细介绍),呼名:小宝宝,休重:8kg,年纪:五岁,体温39 。4℃,心率98次/分鐘,吸气36次/分鐘 。

文章插图
图3 生病博美犬
2.2 临床表现
该犬初期出現持续低烧稽留热,人体体温一直保持在39.零摄氏度~39.5℃ 。口角粘膜轻微黄染,被毛凌乱、没精打采,腹部体格检查腹腔轻按痛感显著,听诊器肠蠕动消退,心血管出現心率不齐,心跳很快 。
2.3 镜检查
采血液滴盐水10倍稀释液,搅拌,加盖玻片,放到400-600倍显微镜下观查,发觉血细胞表层及血液中有摆动的附血细胞体 。

文章插图
图4 博美镜检查結果
2.4 确诊
根据临床医学定期检查镜检查,确诊为附血细胞体感柒 。
2.5 医治
①静脉注射医治,确保人体基础血流量,输犬全血150ml,IM地塞米松2mg;
②护肝改正人体ph酸碱度,古拉丁0.6g 苏打20ml;
③保持治疗法,静注液體和多种多样碳水化合物;
④7天后注入贝尼尔机械纪元并用两个星期,融合抗菌素医治避免 继发感染 。
历经二十多天的医治,该犬各类临床症状基础恢复过来,治愈住院 。
3、汇总与探讨
3.1 该病多产生于夏秋季时节,常见于7-九月份 。该病可产生在全年龄层的犬品种 。该病前期病狗持续低烧、稽留热,而某些、四肢里侧、四肢肢端处出現过敏性紫癜 。现病史太长的会出現肢端萎缩 。中后期出現嘴唇粘膜黄染,肌肤出現黄染,尿里呈茶褐色 。取病狗血液滴一滴盐水10倍稀释液,搅拌,加盖玻片,放到400-600倍显微镜下观查,可发觉血细胞表层及血液中有摆动的各种类型虫体(末期病狗不存在病症),血细胞呈星形或不规律的不规则图形,血涂片用姬姆萨上色,放到油镜暗视野下,由此可见绝大多数血细胞边沿形变 。
文章插图
图5 一切正常的犬血细胞的形状
3.2 该病早期治疗治疗率较高,病发時间越长患病率越高,初期发觉时医治该病的关键 。该病在我国全科医师小动物病发并不是许多 ,非常容易被忽视,等意识到的情况下早已病狗奄奄一息 。因此 初期确诊特别是在关键 。该病前期人体体温多在39.5℃左右出現稽留热轻度新生儿黄疸 。中后期会出現皮下紫癜,胃粘膜流血,出現呕血和泻血,应当立即开展血液图片查验 。
3.3 医治优选药品为血虫净和三氮眯,可是这二种药均存有很大的不良反应,在小动物心电监护不太好的情况下应用有一定的风险性,因此 如果是心电监护欠佳时要先回应心电监护,最好对策是开展全血静脉注射,如人体重度贫血和脾脏肿大先要根据手术治疗切除肝脏 。肝脏肿大或新生儿黄疸的病狗应给与护肝医治和支持治疗 。
3.4 该病中后期很多血细胞融解,融解的血细胞残片很有可能导致尾端血管栓塞,在一些病案上出現的病狗左前腿肘关节下列出現干性坏疽,很有可能便是血管栓塞造成的 。
3.5 该病无专业的预苗能够打疫苗防止,防止该病的关键所在清除病原体和断开传播途径,杜绝带故障小动物、搞好消毒杀菌除虫和清洁卫生工作中是防止该病的根本所在 。
特别声明:本站内容均来自网友提供或互联网,仅供参考,请勿用于商业和其他非法用途。如果侵犯了您的权益请与我们联系,我们将在24小时内删除。
